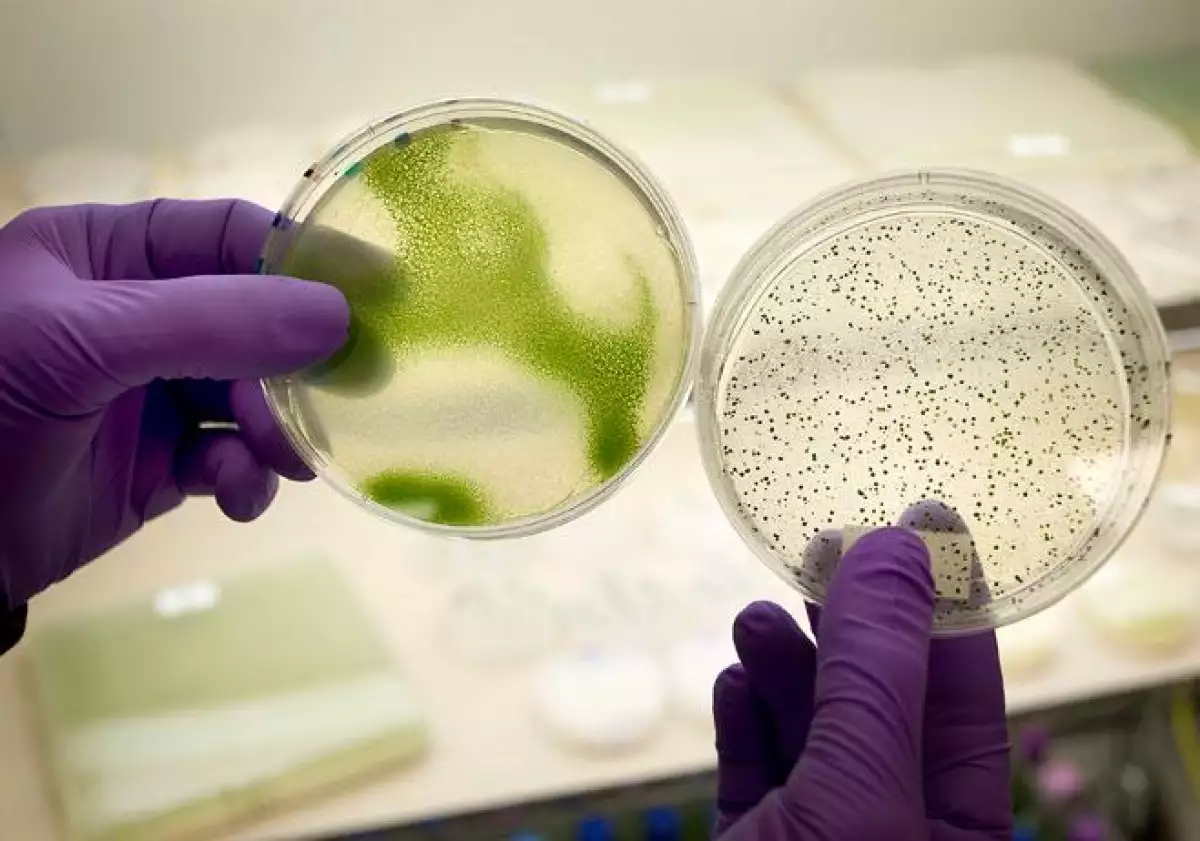

Infografía: ¿Cómo se producen los biocombustibles?
Pemex busca producir gasolinas más amigables con el medio ambiente
Biocombustible
-
(Foto: Autocosmos)
Pemex firmó seis contratos con proveedores de etanol anhidro, el insumo base que en un futuro le permitirá producir gasolinas más amigables con el medio ambiente.
La petrolera adquirirá un monto que oscila entre 8,000 millones y 11,457 millones de pesos de etanol anhidro producido con origen 100% del campo mexicano, mediante contratos a 10 años de vigencia, lo que permitirá adquirir hasta 123 millones de litros al año. En una primera etapa, se venderán 60 mil barriles diarios de gasolina aditivada con etanol en los estados de Tamaulipas, San Luis Potosí y Veracruz.
Así es el proceso para producir los biocombustibles
Publicidad
Newsletter
Recibe en tu correo nuestro boletín
Publicidad